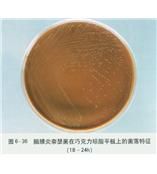
.

信息
屬名Clostridium
種名bifermentans
.
.具體用途研究、質量控制
培養基121
培養溫度37℃
試驗
以加利福尼亞兔為試驗材料,研究了雙酶梭菌制荊對家兔生長及腸道消化酶活性的影響。試驗用45日齡斷奶加利福尼亞仔兔24隻,隨機分為2組,每組12隻,雌雄各半。對照組飼餵基礎日糧,試驗組在基礎日糧中按1g/kg添加雙酶梭菌制荊。飼餵30d後,測定家兔的增重和消化道消化酶活性。結果表明,日糧中添加雙酶梭菌製劑後,可促進家兔的生長和腸道中的消化酶活性,提高飼料的利用率。
【作者單位】:山東省惠民地區衛生防疫站山東省惠民地區衛生防疫站
【關鍵字】:細菌生長庖肉培養基血平板代謝物硫化氫常分布雙酶梭菌生化反應淡水代謝產物
